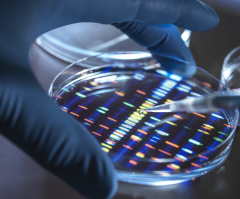
Is engineering a ‘super’ human being a good idea?

Columns
Latest

Can money buy just a little bit of happiness?
Can’t money buy some happiness, just a little — and is it wrong to think that it can?
Is engineering a ‘super’ human being a good idea?
When we start trying to engineer human beings, we are in way over our heads ethically and morally.

Why Zohran Mamdani won and New York will pay a terrible price
How did New York City, arguably the world capital of capitalism, elect a Democratic Socialist (on a good day) and a Communist (on a bad day) mayor?

The biggest danger of all isn’t what you think
No one dies in a tragedy or atrocity that wasn't going to die. Whether you or I leave this earth in an event like one of those or peacefully in our sleep, we all still die. And then what?

3 scary things that Jesus said
Today, as always, you and I are in one of two groups: those with their judgment behind them and those with their judgment ahead of them.

Pa. Democrat compares pro-life efforts to Taliban
What’s happening in Pennsylvania is happening everywhere.

The most predictable scandal in recent sports history
Along with many others, I have been waiting with bated breath for several years now for such a scandal to break.

No kings ... including Jesus?
Did you see that a lot of people don’t want Donald Trump to be the king of America?

Why born-again men and women are needed in Holy Matrimony
The point is that after Pentecost, God had created a new kind of man who did not exist before the coming of the Holy Spirit to personally indwell twice-born men.

When Jesus is insulting
When understood and not superficially dismissed, Jesus is quietly and instinctively insulting to everyone not born again.



















